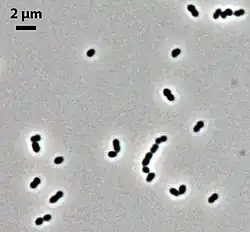

Suipraeoptans
| Suipraeoptans | ||
|---|---|---|
![]() | ||
| Taxonomía | ||
| Dominio: | Bacteria | |
| Reino: | Bacillati | |
| Filo: | Bacillota | |
| Clase: | Clostridia | |
| Orden: | Eubacteriales | |
| Familia: | Lachnospiraceae | |
| Género: |
Suipraeoptans Wylensek et al. 2021 | |
| Especie: | Suipraeoptans intestinalis | |
Suipraeoptans es un género de bacterias grampositivas de la familia Lachnospiraceae. Actualmente (2023) sólo contiene una especie: Suipraeoptans intestinalis.[1] Fue descrita en el año 2021. Su etimología proviene del latín sus (cerdo) y praeoptans (preferencia). El nombre de la especie se refiere a intestino.[2] Es anaerobia estricta, en forma de bacilo corto con una longitud de 0,5 μm. Suele crecer individual o en pares. Temperatura de crecimiento de 37 °C. Tiene un contenido de G+C de 47,7%. Se ha aislado del intestino de un cerdo en Estados Unidos.
Referencias
- ↑ LPSN (ed.). «Genus: Suipraeoptans». lpsn.dsmz.de (en inglés). Consultado el 20 de diciembre de 2023.
- ↑ Wylensek, David; Hitch, Thomas C. A.; Riedel, Thomas; Afrizal, Afrizal; Kumar, Neeraj; Wortmann, Esther; Liu, Tianzhe; Devendran, Saravanan et al. (15 de diciembre de 2020). «A collection of bacterial isolates from the pig intestine reveals functional and taxonomic diversity». Nature Communications 11 (1): 6389. ISSN 2041-1723. PMC 7738495. PMID 33319778. doi:10.1038/s41467-020-19929-w. Consultado el 15 de agosto de 2022.